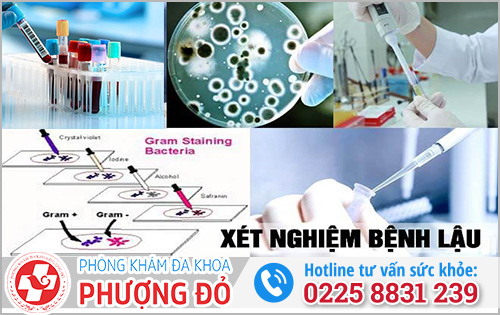

498 Nguyễn Văn Linh, P. vĩnh Niệm, Q. Lê Chân, TP. Hải Phòng
0225 8831 239
Bị lậu lâu ngày nhưng không còn triệu chứng rõ rệt khiến nhiều người thắc mắc: “Lậu mãn tính có xét nghiệm được không?” Thực tế, dù vi khuẩn đã “ẩn sâu” trong cơ thể nhưng vẫn có thể phát hiện thông qua các kỹ thuật xét nghiệm chuyên sâu. Cùng Phòng Khám Đa Khoa Phượng Đỏ tìm hiểu chi tiết trong bài viết để chủ động kiểm tra và điều trị kịp thời nhé.
Lậu mãn tính là giai đoạn bệnh lậu kéo dài lâu ngày nhưng không còn biểu hiện rầm rộ như giai đoạn cấp tính. Nếu ở giai đoạn đầu, người bệnh thường gặp tiểu buốt, tiểu mủ, chảy dịch ở niệu đạo (nam) hoặc khí hư vàng xanh, đau rát khi quan hệ (nữ), thì khi chuyển sang mãn tính, các triệu chứng trở nên mờ nhạt, đôi khi chỉ âm ỉ hoặc xuất hiện rồi biến mất.
Nguyên nhân là do vi khuẩn lậu (Neisseria gonorrhoeae) đã “ẩn náu” sâu trong niêm mạc niệu đạo, cổ tử cung hoặc trực tràng, giảm hoạt động ra bên ngoài nên khó nhận biết bằng mắt thường.
Thêm vào đó, nhiều người tự ý dùng kháng sinh khiến bệnh không khỏi hẳn mà chuyển sang thể “ngủ yên”, chỉ bùng phát khi sức đề kháng yếu.
Chính vì vậy, ở giai đoạn mãn tính, việc chẩn đoán dựa vào triệu chứng không còn đủ, mà cần phải xét nghiệm chuyên sâu để phát hiện mầm bệnh. Đây cũng là lý do vì sao nhiều người nhầm tưởng rằng lậu mãn tính không thể xét nghiệm được.
Nhiều người lo lắng rằng lậu mãn tính có xét nghiệm được không, vì bệnh đã kéo dài lâu ngày, triệu chứng gần như biến mất và vi khuẩn “ẩn náu” sâu trong cơ thể. Thực tế, câu trả lời là CÓ, nhưng việc xét nghiệm sẽ khó hơn và đòi hỏi kỹ thuật chuyên sâu hơn so với giai đoạn cấp tính.

Lậu mãn tính có xét nghiệm được không?
Ở giai đoạn mãn tính, vi khuẩn lậu (Neisseria gonorrhoeae) không còn hoạt động mạnh như trước mà ẩn sâu trong niêm mạc niệu đạo, cổ tử cung hoặc trực tràng. Do đó, nếu chỉ dựa vào xét nghiệm thông thường, kết quả có thể âm tính giả, tức là bệnh vẫn tồn tại nhưng test không phát hiện được.
Một số yếu tố ảnh hưởng đến độ chính xác của xét nghiệm trong giai đoạn lậu mãn tính gồm:
Tuy nhiên, với các kỹ thuật hiện đại như PCR (khuếch đại gen), nuôi cấy vi khuẩn, xét nghiệm dịch niệu đạo – cổ tử cung chuyên sâu, bác sĩ hoàn toàn có thể phát hiện chính xác vi khuẩn lậu ngay cả khi bệnh đã chuyển sang mãn tính.
Chính vì vậy, nếu bạn nghi ngờ mắc bệnh và băn khoăn “lậu mãn tính có xét nghiệm được không”, đừng tự chẩn đoán hoặc trì hoãn khám bệnh.
Việc thăm khám sớm sẽ giúp bạn được lấy mẫu đúng kỹ thuật, xét nghiệm chuyên sâu và chẩn đoán chính xác nguyên nhân, từ đó điều trị dứt điểm, tránh biến chứng nguy hiểm về sau.
Như đã phân tích ở phần trên, dù bệnh đã chuyển sang giai đoạn mãn tính, việc xét nghiệm lậu vẫn có thể thực hiện được nếu lựa chọn đúng phương pháp. Vậy lậu mãn tính xét nghiệm bằng phương pháp gì để cho kết quả chính xác nhất?
Trong thực tế, bác sĩ thường phối hợp nhiều kỹ thuật khác nhau – từ truyền thống đến hiện đại – để vừa phát hiện vi khuẩn, vừa đánh giá khả năng kháng thuốc, giúp quá trình điều trị đạt hiệu quả tối ưu.
Những phương pháp xét nghiệm bệnh Lậu mãn tính
Đây là phương pháp kinh điển được sử dụng từ lâu. Bác sĩ sẽ lấy mẫu dịch ở niệu đạo (hoặc cổ tử cung với nữ) để soi tươi và nhuộm Gram, phát hiện vi khuẩn lậu qua hình dạng đặc trưng. Ngoài ra, mẫu cũng có thể được nuôi cấy để tìm sự phát triển của Neisseria gonorrhoeae.
Công nghệ PCR (Polymerase Chain Reaction) hiện là phương pháp hiện đại và chính xác nhất để phát hiện vi khuẩn lậu. Phương pháp này khuếch đại vật chất di truyền (ADN) của vi khuẩn trong mẫu dịch hoặc nước tiểu, giúp phát hiện kể cả khi mật độ vi khuẩn cực thấp.
Vì vậy, nếu bạn thắc mắc “lậu mãn tính có thể xét nghiệm bằng PCR không” thì hoàn toàn có thể, và thậm chí đây là lựa chọn ưu tiên được các phòng khám chuyên khoa khuyến nghị.
Phương pháp này thuận tiện và không xâm lấn, thường dùng cho nam giới. Mẫu nước tiểu đầu dòng (phần đầu tiên khi đi tiểu) chứa dịch từ niệu đạo, giúp phát hiện vi khuẩn lậu.
Tuy nhiên, lậu mãn tính có xét nghiệm nước tiểu được không? Câu trả lời là có thể, nhưng độ chính xác thấp hơn PCR hoặc lấy mẫu trực tiếp, nhất là khi vi khuẩn trú sâu trong mô. Vậy nếu chỉ xét nghiệm nước tiểu có phát hiện bệnh lậu không? Tìm hiểu chi tiết ngay tại đây.

Xét nghiệm lậu mãn tính bằng nước tiểu
Với những ca lậu kéo dài, bác sĩ có thể chỉ định xét nghiệm máu để tìm kháng thể hoặc kháng nguyên của vi khuẩn. Mục đích nhằm xác định cơ thể đã từng nhiễm lậu hay chưa.
Do đó, nếu bạn đang phân vân “lậu mãn tính có xét nghiệm máu được không”, thì hoàn toàn có, nhưng cần hiểu rằng phương pháp này chỉ hỗ trợ phát hiện gián tiếp, không thay thế được PCR hoặc nuôi cấy.
Sau khi xác định có vi khuẩn lậu, bác sĩ sẽ tiến hành nuôi cấy và làm kháng sinh đồ để xem vi khuẩn còn nhạy cảm với loại thuốc nào, tránh tình trạng kháng thuốc. Đây là bước quan trọng giúp điều trị dứt điểm lậu mãn tính và ngăn ngừa tái phát.
Mỗi phương pháp có ưu và nhược điểm riêng, nhưng với lậu mãn tính, PCR và nuôi cấy kháng sinh đồ vẫn là hai kỹ thuật cho kết quả chính xác và an toàn nhất. Việc lựa chọn phương pháp phù hợp nên được bác sĩ chuyên khoa chỉ định, tùy tình trạng cụ thể của từng người bệnh.
Sau khi đã hiểu rõ các kỹ thuật xét nghiệm, câu hỏi tiếp theo là: khi nào cần đi xét nghiệm lậu mãn tính? Việc xác định đúng thời điểm sẽ giúp tăng độ chính xác của kết quả, đồng thời hỗ trợ bác sĩ chẩn đoán sớm và điều trị kịp thời.
Do đó, khi xuất hiện triệu chứng dưới đây mờ nhạt nhưng kéo dài dù không còn rầm rộ nhưng người bệnh cũng nên đi xét nghiệm lậu mãn tính ngay:

Đây là thời điểm nên đi xét nghiệm lậu mãn tính
Đặc biệt là trong những trường hợp có nguy cơ cao dưới đây, để tránh lây lan hoặc biến chứng nặng hơn:
Hoặc nếu bạn đã đang dùng kháng sinh, nên ngưng ít nhất 5–7 ngày trước khi xét nghiệm để tránh âm tính giả. Đây là khuyến nghị quan trọng giúp kết quả xét nghiệm lậu mãn tính chính xác hơn.
Việc xét nghiệm lậu mãn tính tại cơ sở chuyên khoa không chỉ giúp phát hiện chính xác vi khuẩn lậu, mà còn mang lại nhiều lợi ích thiết thực như: giảm nguy cơ âm tính giả, tiết kiệm thời gian và chi phí, điều trị trực tiếp cũng như kiểm soát bệnh lâu dài hiệu quả hơn.
Vì vậy, nếu bạn đang băn khoăn “xét nghiệm lậu mãn tính ở đâu tại Hải Phòng uy tín và chính xác?”, hãy tham khảo những tiêu chí quan trọng dưới đây trước khi lựa chọn cơ sở thăm khám.
Tất cả những tiêu chí trên đều được Phòng khám Đa khoa Phượng Đỏ đáp ứng đầy đủ và toàn diện. Đây là một trong những địa chỉ xét nghiệm và điều trị bệnh lậu uy tín tại Hải Phòng, được đông đảo người dân tin tưởng lựa chọn trong suốt nhiều năm qua.

Lậu mãn tính tại đâu xét nghiệm uy tín ở Hải Phòng?
Phòng khám Phượng Đỏ hiện đầu tư hệ thống xét nghiệm hiện đại như PCR, nhuộm Gram, nuôi cấy – kháng sinh đồ, giúp phát hiện chính xác vi khuẩn lậu ngay cả khi mật độ thấp ở giai đoạn mãn tính.
Quy trình lấy mẫu, phân tích và trả kết quả được thực hiện khép kín, nhanh chóng và bảo mật tuyệt đối, đảm bảo không để xảy ra sai lệch hay rò rỉ thông tin cá nhân.
Đặc biệt, đội ngũ bác sĩ chuyên khoa bệnh xã hội giàu kinh nghiệm trực tiếp thăm khám, đọc kết quả và đưa ra phác đồ điều trị phù hợp từng trường hợp.
Người bệnh khi đến đây không chỉ được xét nghiệm chính xác, mà còn được hỗ trợ điều trị toàn diện – từ tư vấn, theo dõi đến tái khám, giúp kiểm soát bệnh hiệu quả và hạn chế tái phát.
Với thời gian làm việc linh hoạt (8h00 – 20h00 tất cả các ngày, kể cả Chủ nhật và ngày lễ), chi phí niêm yết công khai, cùng chính sách ưu đãi cho người đặt lịch trước, Phòng khám Đa khoa Phượng Đỏ là lựa chọn lý tưởng cho những ai đang tìm kiếm địa chỉ xét nghiệm lậu mãn tính uy tín, kín đáo và hiệu quả tại Hải Phòng.
Nhiều người e ngại chi phí nên chần chừ thăm khám, nhưng thực tế giá xét nghiệm lậu mãn tính không quá cao và có thể linh hoạt tùy theo từng trường hợp. Mức phí cụ thể phụ thuộc vào các yếu tố sau:

Chi phí xét nghiệm lậu mãn tính
Sau khi lựa chọn được cơ sở y tế uy tín, người bệnh cần nắm rõ một số lưu ý quan trọng khi xét nghiệm bệnh lậu mãn tính để kết quả đạt độ chính xác cao nhất. Dưới đây là những điểm cần đặc biệt chú ý:
Kết luận, lậu mãn tính có xét nghiệm được không? — Câu trả lời là hoàn toàn có thể, nhưng để đạt kết quả chính xác, người bệnh cần thực hiện tại cơ sở chuyên khoa uy tín, áp dụng đầy đủ các phương pháp hiện đại và tuân thủ đúng hướng dẫn trước khi lấy mẫu. Hãy liên hệ ngay
Hotline 0225 8831 239 hoặc nhắn tin tại đây
để được xét nghiệm, tư vấn và điều trị kịp thời.